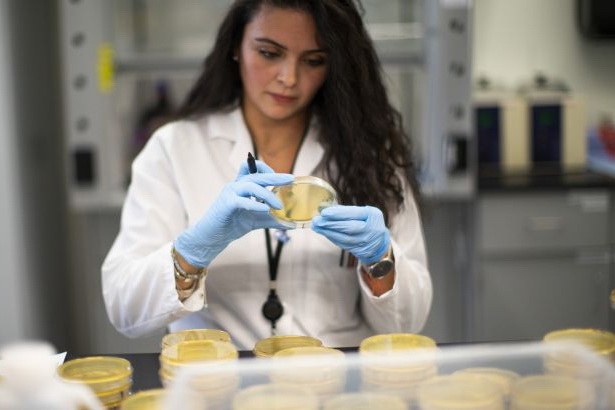

Команда ВОЗ дала некоторую надежду миру, столкнувшемуся с новой волной, что 2022 год станет годом прекращения пандемии, которая уже унесла жизни более 5,6 млн человек во всем мире.
Надежды возлагаются на разработку вакцин второго и третьего поколения, а также на дальнейшее развитие противомикробных препаратов и других инноваций. Об этом сообщает Reuters.
"Мы надеемся, что это заболевание станет относительно легким, и мы сможем его легко предотвратить и лечить", - сказал на брифинге главный эксперт ВОЗ по чрезвычайным ситуациям Майк Райан.Генеральный директор ВОЗ Тедрос Аданом Гебреисус в свою очередь заявил, что Китай, где коронавирус SARS-CoV-2 был впервые обнаружен в конце 2019 года, должен предоставить данные и информацию, связанные с его происхождением, чтобы помочь в дальнейшем реагировании.
"Если мы сможем свести передачу вируса к минимуму, то мы сможем положить конец пандемии", - заявил Тедрос.
Автор: Анна Полисученко
![]() |
Gorod`ской дозор |
![]() |
Фоторепортажи и галереи |
![]() |
Видео |
![]() |
Интервью |
![]() |
Блоги |
| Новости компаний | |
| Сообщить новость! | |
![]() |
Погода |
| Архив новостей | |